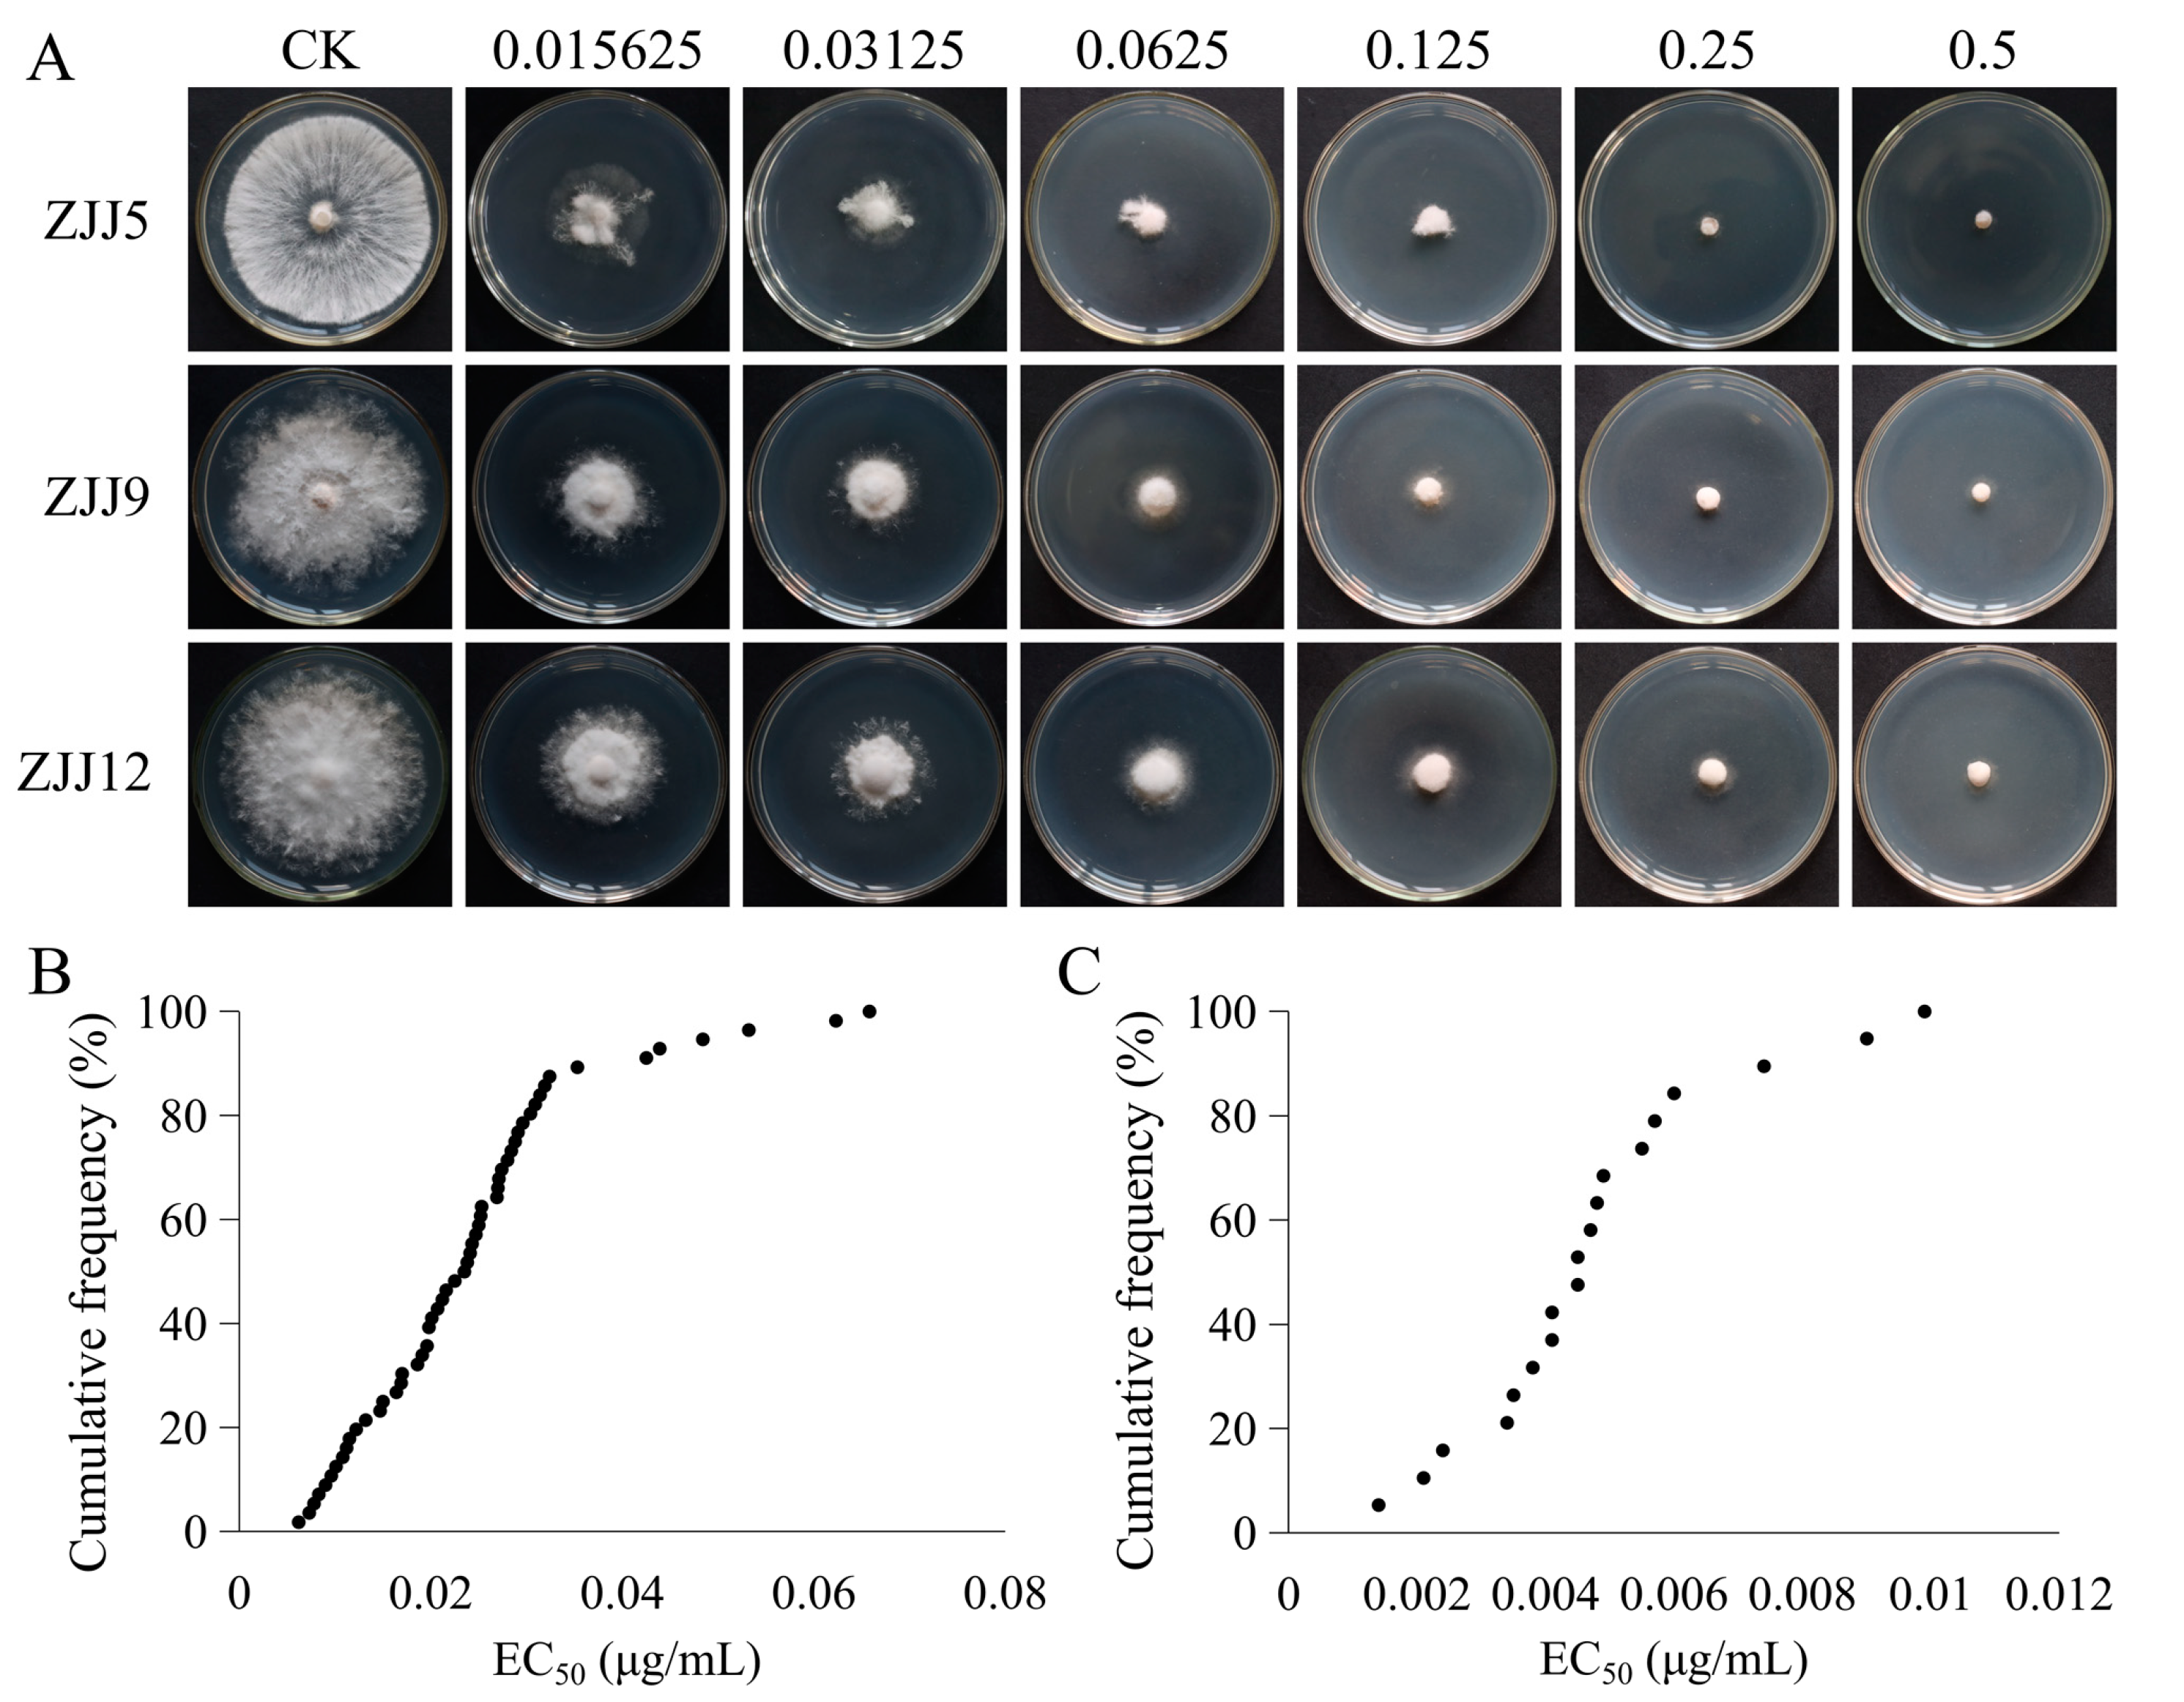
Agronomy 13 01340 g003

Inhibitory Effect and Control Efficacy of Picoxystrobin against Neopestalotiopsis clavispora, Causing Vine Tea Leaf Blight
Abstract
1. Introduction
2. Materials and Methods
2.1. Fungal Isolation and Identification
2.2. DNA Extraction and PCR Assays
2.3. Fungicide and Media
2.4. Sensitivity of Mycelial Growth of Neopestalotiopsis clavispora to Picoxystrobin
2.5. Sensitivity of Conidium Germination of N. clavispora to Picoxystrobin
2.6. Effect of Picoxystrobin on Pycnidium Formation of N. clavispora
2.7. Cell Membrane Permeability as Affected by Picoxystrobin
2.8. ATP Production Assays (1)
2.9. Control Efficacy of Picoxystrobin on Vine Tea
2.10. In Vitro Induction of Picoxystrobin-Resistant Mutants
2.11. Resistance Stability Assays
2.12. Sequencing Analysis of N. clavispora Cytb Gene
2.13. Cross-Resistance Assays
2.14. Fitness Tests
2.15. Data Analysis
3. Results
3.1. Morphological and Molecular Characteristics of Fungal Isolates
3.2. Sensitivity Distribution of N. clavispora to Picoxystrobin Based on Mycelial Growth Inhibition
3.3. Sensitivity Distribution of N. clavispora to Picoxystrobin Based on Conidium Germination Inhibition
3.4. Effect of Picoxystrobin on Mycelial Morphology of N. clavispora
3.5. Effect of Picoxystrobin on Pycnidium Formation of N. clavispora
3.6. Effect of Picoxystrobin on Cell Membrane Permeability of N. clavispora
3.7. Picoxystrobin Inhibited ATP Biosynthesis in N. clavispora
3.8. In Planta Control Efficacy of Picoxystrobin against N. clavispora
3.9. Cross-Resistance between Picoxystrobin and Other Fungicides in N. clavispora
3.10. Analysis of Cytb Gene in Picoxystrobin-Resistant Mutants
3.11. Competitive Abilities of Picoxystrobin-Resistant Mutants of N. clavispora
4. Discussion
5. Conclusions
Supplementary Materials
Author Contributions
Funding
Data Availability Statement
Conflicts of Interest
References
- Yang, C.S.; Chen, G.; Wu, Q. Recent scientific studies of a traditional Chinese medicine, tea, on prevention of chronic diseases. J. Tradit. Complement. Med. 2014, 4, 17–23. [Google Scholar] [CrossRef] [PubMed]
- Patel, S.; Sharma, V.; Chauhan, N.S.; Thakur, M.; Dixit, V.K. Hair growth: Focus on herbal therapeutic agent. Curr. Drug Discov. Technol. 2015, 12, 21–42. [Google Scholar] [CrossRef] [PubMed]
- Zhang, Q.L.; Zhao, Y.F.; Zhang, M.Y.; Zhang, Y.L.; Ji, H.F.; Shen, L. Recent advances in research on vine tea, a potential and functional herbal tea with dihydromyricetin and myricetin as major bioactive compounds. J. Pharm. Anal. 2021, 11, 555–563. [Google Scholar] [CrossRef] [PubMed]
- Wang, C.; Xiong, W.; Perumalla, S.R.; Fang, J.G.; Sun, C.C. Solid-state characterization of optically pure (+) dihydromyricetin extracted from Ampelopsis grossedentata leaves. Int. J. Pharm. 2016, 511, 245–252. [Google Scholar] [CrossRef] [PubMed]
- Xie, K.; He, X.; Chen, K.Y.; Chen, J.H.; Sakao, K.; Hou, D. Antioxidant properties of a traditional vine tea, Ampelopsis grossedentata. Antioxidants 2019, 8, 295. [Google Scholar] [CrossRef] [PubMed]
- Carneiro, R.C.V.; Wang, H.J.; Duncan, S.E.; O’Keefe, S.F. Flavor compounds in vine tea (Ampelopsis grossedentata) infusions. Food Sci. Nutr. 2020, 8, 4505–4511. [Google Scholar] [CrossRef] [PubMed]
- Ye, L.; Wang, H.; Duncan, S.E.; Eigel, W.N.; O’Keefe, S.F. Antioxidant activities of vine tea (Ampelopsis grossedentata) extract and its major component dihydromyricetin in soybean oil and cooked ground beef. Food Chem. 2015, 172, 416–422. [Google Scholar] [CrossRef]
- Zhang, X.; Xu, Y.; Xue, H.; Jiang, G.C.; Liu, X.J. Antioxidant activity of vine tea (Ampelopsis grossedentata) extract on lipid and protein oxidation in cooked mixed pork patties during refrigerated storage. Food Sci. Nutr. 2019, 7, 1735–1745. [Google Scholar] [CrossRef]
- Bartlett, D.W.; Clough, J.M.; Godwin, J.R.; Hall, A.A.; Hamer, M.; Parr-Dobrzanski, B. The strobilurin fungicides. Pest Manag. Sci. 2002, 58, 649–662. [Google Scholar] [CrossRef]
- Sabbahi, R.; Oliveira, D.; Marceau, J. Influence of honey bee (Hymenopetra: Apidae) density on the production of canola (Cruciferae: Brassicaceae). J. Econ. Entomol. 2005, 98, 367–372. [Google Scholar] [CrossRef]
- Keith, L.M.; Velasquez, M.E.; Zee, F.T. Identification and characterization of Pestalotiopsis spp. causing scab disease of guava, Psidium guajava, in Hawaii. Plant Dis. 2006, 90, 16–23. [Google Scholar] [CrossRef] [PubMed]
- Chen, Y.; Zeng, L.; Shu, N.; Jiang, M.; Wang, H.; Huang, Y.; Tong, H. Pestalotiopsis-like species causing gray blight disease on Camellia sinensis in China. Plant Dis. 2018, 102, 98–106. [Google Scholar] [CrossRef] [PubMed]
- Shu, J.; Yu, Z.H.; Sun, W.X.; Zhao, J.; Li, Q.L.; Tang, L.H.; Guo, T.X.; Huang, S.P.; Mo, J.Y.; Hsiang, T.; et al. Identification and characterization of Pestalotioid fungi causing leaf spots on mango in southern China. Plant Dis. 2020, 104, 1207–1213. [Google Scholar] [CrossRef] [PubMed]
- Udayanga, D.; Castlebury, L.A.; Rossman, A.Y.; Chukeatirote, E.; Hyde, K.D. Insights into the genus Diaporthe: Phylogenetic species delimitation in the D. eres species complex. Fungal Divers. 2014, 67, 203–229. [Google Scholar] [CrossRef]
- Duan, Y.B.; Ge, C.Y.; Liu, S.M.; Chen, C.J.; Zhou, M.G. Effect of phenylpyrrole fungicide fludioxonil on morphological and physiological characteristics of Sclerotinia sclerotiorum. Pestic. Biochem. Physiol. 2013, 106, 61–67. [Google Scholar] [CrossRef]
- Duan, Y.B.; Ge, C.Y.; Liu, S.M.; Wang, J.X.; Zhou, M.G. A two-component histidine kinase Shk1 controls stress response, sclerotial formation and fungicide resistance in Sclerotinia sclerotiorum. Mol. Plant Pathol. 2013, 14, 708–718. [Google Scholar] [CrossRef]
- Duan, Y.B.; Xiu, Q.; Li, H.R.; Li, T.; Wang, J.X.; Zhou, M.G. Pharmacological characteristics and control efficacy of a novel SDHI fungicide pydiflumetofen against Sclerotinia sclerotiorum. Plant Dis. 2019, 103, 77–82. [Google Scholar] [CrossRef]
- Li, T.; Xiu, Q.; Zhang, J.; Wang, J.X.; Duan, Y.B.; Zhou, M.G. Pharmacological characteristics and efficacy of fluazinam against Corynespora cassiicola, causing cucumber target spot in greenhouses. Plant Dis. 2020, 104, 2449–2454. [Google Scholar] [CrossRef]
- Yuan, S.Q.; Wang, Y.C.; Lei, L.; Hong, J.Y.; Yi, T.Y.; Hong, Y.Y. First report of Pestalotiopsis microspora causing leaf spot on moyeam in China. Plant Dis. 2021, 106, 1996. [Google Scholar] [CrossRef]
- Bi, Y.; Cui, X.L.; Lu, X.L.; Cai, M.; Liu, X.L.; Hao, J.J.J. Baseline sensitivity of natural population and resistance of mutants in Phytophthora capsici to zoxamide. Phytopathology 2011, 101, 1104–1111. [Google Scholar] [CrossRef]
- Mao, X.W.; Wu, Z.W.; Bi, C.W.; Wang, J.X.; Zhao, F.F.; Gao, J.; Hou, Y.P.; Zhou, M.G. Molecular and biochemical characterization of pydiflumetofen resistant isolates of Didymella bryoniae. J. Agric. Food Chem. 2020, 68, 9120–9130. [Google Scholar] [CrossRef] [PubMed]
- Brandt, U.; Schagger, H.; Jagow, G. Characterisation of binding of the methox-yacrylate inhibitors mitochondrial cytochrome c reductase. Eur. J. Biochem. 1988, 173, 499–506. [Google Scholar] [CrossRef] [PubMed]
- Qu, X.P.; Li, J.S.; Wang, J.X.; Wu, L.Y.; Wang, Y.F.; Chen, C.J.; Zhou, M.G.; Hou, Y.P. Effects of the dinitroaniline fungicide fluazinam on Fusarium fujikuroi and rice. Pestic. Biochem. Physiol. 2018, 152, 98–105. [Google Scholar] [CrossRef] [PubMed]
- Jones, P.J.; Jew, S. Functional food development: Concept to reality. Trends Food Sci. Technol. 2007, 18, 387–390. [Google Scholar] [CrossRef]
- Gao, J.; Liu, B.; Ning, Z.; Zhao, R.; Zhang, A.; Wu, Q. Characterization and antioxidant activity of flavonoid-rich extracts from leaves of Ampelopsis grossedentata. J. Food Biochem. 2009, 33, 808–820. [Google Scholar] [CrossRef]
- Zheng, X.J.; Xiao, H.; Zeng, Z.; Sun, Z.W.; Lei, C.; Dong, J.Z.; Wang, Y. Composition and serum antioxidation of the main flavonoids from fermented vine tea (Ampelopsis grossedentata). J. Funct. Foods 2014, 9, 290–294. [Google Scholar] [CrossRef]
- Xie, J.; Wei, J.G.; Wang, K.W.; Luo, J.; Wu, Y.J.; Luo, J.T.; Yang, X.H.; Yang, X.B. Three phytotoxins produced by Neopestalotiopsis clavispora, the causal agent of ring spot on Kadsura coccinea. Microbiol. Res. 2020, 238, 126531. [Google Scholar] [CrossRef]
- Shi, J.; Zhang, X.; Liu, Y.; Zhang, Z.; Wang, Z.; Xue, C.; Ma, Y.; Wang, F. First report of Neopestalotiopsis clavispora causing calyx and receptacle blight on strawberry in China. Plant Dis. 2022, 106, 1307. [Google Scholar] [CrossRef]
- Cowger, C.; Meyers, E.; Whetten, R. Sensitivity of the U.S. wheat powdery mildew population to quinone outside inhibitor fungicides and determination of the complete Blumeria graminis f. sp. Tritici cytochrome b gene. Phytopathology 2022, 112, 249–260. [Google Scholar] [CrossRef]
- Abate, M.; Festa, A.; Falco, M.; Lombardi, A.; Luce, A.; Grimaldi, A.; Zappavigna, S.; Sperlongano, P.; Irace, C.; Caraglia, M.; et al. Mitochondria as playmakers of apoptosis, autophagy and senescence. Semin. Cell Dev. Biol. 2020, 98, 139–153. [Google Scholar] [CrossRef]
- van der Bliek, A.M.; Sedensky, M.M.; Morgan, P.G. Cell biology of the mitochondrion. Genetics 2017, 207, 843–871. [Google Scholar] [CrossRef] [PubMed]
- Duan, Y.B.; Lu, F.; Zhou, Z.H.; Zhao, H.H.; Zhang, J.; Mao, Y.S.; Li, M.X.; Wang, J.X.; Zhou, M.G. Quinone outside inhibitors affect DON biosynthesis, mitochondrial structure and toxisome formation in Fusarium graminearum. J. Hazard. Mater. 2020, 398, 122908. [Google Scholar] [CrossRef] [PubMed]
- Chen, Y.L.; Mao, X.W.; Wang, J.X.; Wu, L.Y.; Zhou, M.G.; Hou, Y.P. Activity of the dinitroaniline fungicide fluazinam against Bipolaris maydis. Pestic. Biochem. Physiol. 2018, 148, 8–15. [Google Scholar] [CrossRef] [PubMed]
- Mao, X.W.; Wang, Y.F.; Hou, Y.P.; Zhou, M.G. Activity of the succinate dehydrogenase inhibitor fungicide penthiopyrad against Sclerotinia sclerotiorum. Plant Dis. 2020, 104, 2696–2703. [Google Scholar] [CrossRef] [PubMed]
- Chen, C.J.; Yu, J.J.; Bi, C.W.; Zhang, Y.N.; Xu, J.Q.; Wang, J.X.; Zhou, M.G. Mutations in a beta-tubulin confer resistance of Gibberella zeae to benzimidazole fungicides. Phytopathology 2009, 99, 1403–1411. [Google Scholar] [CrossRef]
- Sun, H.Y.; Wang, H.C.; Chen, Y.; Li, H.X.; Chen, C.J.; Zhou, M.G. Multiple resistance of Botrytis cinerea from vegetable crops to carbendazim, diethofencarb, procymidone, and pyrimethanil in China. Plant Dis. 2010, 94, 551–556. [Google Scholar] [CrossRef]
- Duan, Y.B.; Yang, Y.; Wang, J.X.; Chen, C.J.; Steinberg, G.; Fraaije, B.A.; Zhou, M.G. Simultaneous detection of multiple benzimidazole-eesistant β-tubulin variants of Botrytis cinerea using loop-mediated isothermal amplification. Plant Dis. 2018, 102, 2016–2024. [Google Scholar] [CrossRef]
- Hou, Y.P.; Qu, X.P.; Mao, X.W.; Kuang, J.; Duan, Y.B.; Song, X.S.; Wang, J.X.; Chen, C.J.; Zhou, M.G. Resistance mechanism of Fusarium fujikuroi to phenamacril in the field. Pest Manag. Sci. 2018, 74, 607–616. [Google Scholar] [CrossRef]
- Yang, Y.; Li, M.X.; Duan, Y.B.; Li, T.; Shi, Y.Y.; Zhao, D.L.; Zhou, Z.H.; Xin, W.J.; Wu, J.; Pan, X.Y.; et al. A new point mutation in β2-tubulin confers resistance to carbendazim in Fusarium asiaticum. Pestic. Biochem. Physiol. 2018, 145, 15–21. [Google Scholar] [CrossRef]
- Degli Esposti, M.; De Vries, S.; Crimi, M.; Ghelli, A.; Patarnello, T.; Meyer, A. Mitochondrial cytochrome b: Evolution and structure of the protein. Biochim. Biophys. Acta 1993, 1143, 243–271. [Google Scholar] [CrossRef]
- Gisi, U.; Sierotzki, H.; Cook, A.; McCaffery, A. Mechanisms influencing the evolution of resistance to Qo inhibitor fungicides. Pest Manag. Sci. 2002, 58, 859–867. [Google Scholar] [CrossRef] [PubMed]
- Fernandez-Ortuno, D.; Tores, J.A.; de Vicente, A.; Perez-Garcia, A. Field resistance to QoI fungicides in Podosphaera fusca is not supported by typical mutations in the mitochondrial cytochrome b gene. Pest Manag Sci. 2008, 64, 694–702. [Google Scholar] [CrossRef] [PubMed]
- Fernandez-Ortuno, D.; Tores, J.A.; de Vicente, A.; Perez-Garcia, A. Mechanisms of resistance to QoI fungicides in phytopathogenic fungi. Int. Microbiol. 2008, 11, 1–9. [Google Scholar] [PubMed]
- Qiu, J.B.; Huang, T.T.; Xu, J.Q.; Bi, C.W.; Chen, C.J.; Zhou, M.G. β-tubulins in Gibberella zeae: Their characterization and contribution to carbendazim resistance. Pest Manag. Sci. 2012, 68, 1191–1198. [Google Scholar] [CrossRef]
- Zhang, L.G.; Li, B.C.; Zhang, Y.; Jia, X.J.; Zhou, M.G. Hexokinase plays a critical role in deoxynivalenol (DON) production and fungal development in Fusarium graminearum. Mol. Plant Pathol. 2016, 17, 16–28. [Google Scholar] [CrossRef]
- Zhou, Z.H.; Duan, Y.B.; Zhou, M.G. Carbendazim-resistance associated β2-tubulin substitutions increase deoxynivalenol biosynthesis by reducing the interaction between β2-tubulin and IDH3 in Fusarium graminearum. Environ. Microbiol. 2020, 22, 598–614. [Google Scholar] [CrossRef]
- Duan, Y.B.; Yang, Y.; Wang, J.X.; Liu, C.C.; He, L.L.; Zhou, M.G. Development and application of loop-mediated isothermal amplification for detecting the highly benzimidazole-resistant isolates in Sclerotinia sclerotiorum. Sci. Rep. 2015, 5, 17278. [Google Scholar] [CrossRef]
- Shao, W.Y.; Zhao, Y.F.; Ma, Z.H. Advances in understanding fungicide resistance in Botrytis cinerea in China. Phytopathology 2021, 111, 455–643. [Google Scholar] [CrossRef]
- Chin, K.M.; Chavaillaz, D.; Kaesbohrer, M.; Staub, T.; Felsenstein, F.G. Characterizing resistance risk of Erysiphe graminis f.sp. tritici to strobilurins. Crop Protect. 2001, 20, 87–96. [Google Scholar] [CrossRef]

| Isolates | Picoxystrobin | Azoxystrobin | Pyraclostrobin | Difenoconazole | Phenamacril | Carbendazim | ||||||
|---|---|---|---|---|---|---|---|---|---|---|---|---|
| EC50 (µg/mL) a | RF b | EC50 (µg/mL) a | RF b | EC50 (µg/mL) a | RF b | EC50 (µg/mL) a | RF b | EC50 (µg/mL) a | RF b | EC50 (µg/mL) a | RF b | |
| ZJJ5 | 0.025 ± 0.0042 d | 0.014 ± 0.0021 c | 0.006 ± 0.0012 b | 1.00 ± 0.084 bc | 0.97 ± 0.078 b | 0.075 ± 0.0063 b | ||||||
| ZJJ5-K2 | 0.32 ± 0.014 c | 12.80 | 0.014 ± 0.0023 c | 1.00 | 0.006 ± 0.0014 b | 1.00 | 0.97 ± 0.074 c | 0.97 | 1.05 ± 0.085 b | 1.08 | 0.072 ± 0.0052 b | 0.96 |
| ZJJ5-K3 | 3.22 ± 0.31 a | 128.80 | 1.03 ± 0.092 a | 73.57 | 0.93 ± 0.081 a | 155.00 | 3.61 ± 0.30 a | 3.61 | 2.05 ± 0.10 a | 2.11 | 0.13 ± 0.0084 a | 1.73 |
| ZJJ5-K5 | 0.99 ± 0.087 b | 39.60 | 0.036 ± 0.0063 b | 2.57 | 0.006 ± 0.0011 b | 1.00 | 1.16 ± 0.090 b | 1.16 | 0.96 ± 0.081 b | 0.99 | 0.073 ± 0.0063 b | 0.97 |
| Strains | Colony Diameter (cm) * | Dry Weight (g) * | Conidia Concentration (×105/mL) * | Lesion Diameter (mm) * |
|---|---|---|---|---|
| ZJJ5 | 6.79 ± 0.12 a | 0.66 ± 0.11 a | 9.70 ± 0.53 a | 13.5 ± 1.4 a |
| ZJJ5-K2 | 6.63 ± 0.09 a | 0.48 ± 0.10 ab | 8.53 ± 0.21 b | 7.0 ± 0.6 b |
| ZJJ5-K3 | 3.81 ± 0.1 b | 0.07 ± 0.02 c | 3.80 ± 0.36 c | 4.7 ± 0.5 c |
| ZJJ5-K5 | 6.68 ± 0.13 a | 0.40 ± 0.06 b | 7.93 ± 0.31 b | 6.3 ± 0.8 b |
Disclaimer/Publisher’s Note: The statements, opinions and data contained in all publications are solely those of the individual author(s) and contributor(s) and not of MDPI and/or the editor(s). MDPI and/or the editor(s) disclaim responsibility for any injury to people or property resulting from any ideas, methods, instructions or products referred to in the content. |
© 2023 by the authors. Licensee MDPI, Basel, Switzerland. This article is an open access article distributed under the terms and conditions of the Creative Commons Attribution (CC BY) license (https://creativecommons.org/licenses/by/4.0/).
Share and Cite
Zhou, Z.; Wang, Y.; Duan, Y.; He, Y.; Liu, S.; Chen, Y.; Deng, W.; Li, C.; Hu, W.; Gu, Y.; et al. Inhibitory Effect and Control Efficacy of Picoxystrobin against Neopestalotiopsis clavispora, Causing Vine Tea Leaf Blight. Agronomy 2023, 13, 1340. https://doi.org/10.3390/agronomy13051340
Zhou Z, Wang Y, Duan Y, He Y, Liu S, Chen Y, Deng W, Li C, Hu W, Gu Y, et al. Inhibitory Effect and Control Efficacy of Picoxystrobin against Neopestalotiopsis clavispora, Causing Vine Tea Leaf Blight. Agronomy. 2023; 13(5):1340. https://doi.org/10.3390/agronomy13051340
Chicago/Turabian StyleZhou, Zehua, Yicai Wang, Yabing Duan, Yannan He, Shuang Liu, Yan Chen, Wucheng Deng, Chunping Li, Weijun Hu, Youjun Gu, and et al. 2023. "Inhibitory Effect and Control Efficacy of Picoxystrobin against Neopestalotiopsis clavispora, Causing Vine Tea Leaf Blight" Agronomy 13, no. 5: 1340. https://doi.org/10.3390/agronomy13051340
APA StyleZhou, Z., Wang, Y., Duan, Y., He, Y., Liu, S., Chen, Y., Deng, W., Li, C., Hu, W., Gu, Y., Tang, Y., & Yi, T. (2023). Inhibitory Effect and Control Efficacy of Picoxystrobin against Neopestalotiopsis clavispora, Causing Vine Tea Leaf Blight. Agronomy, 13(5), 1340. https://doi.org/10.3390/agronomy13051340

